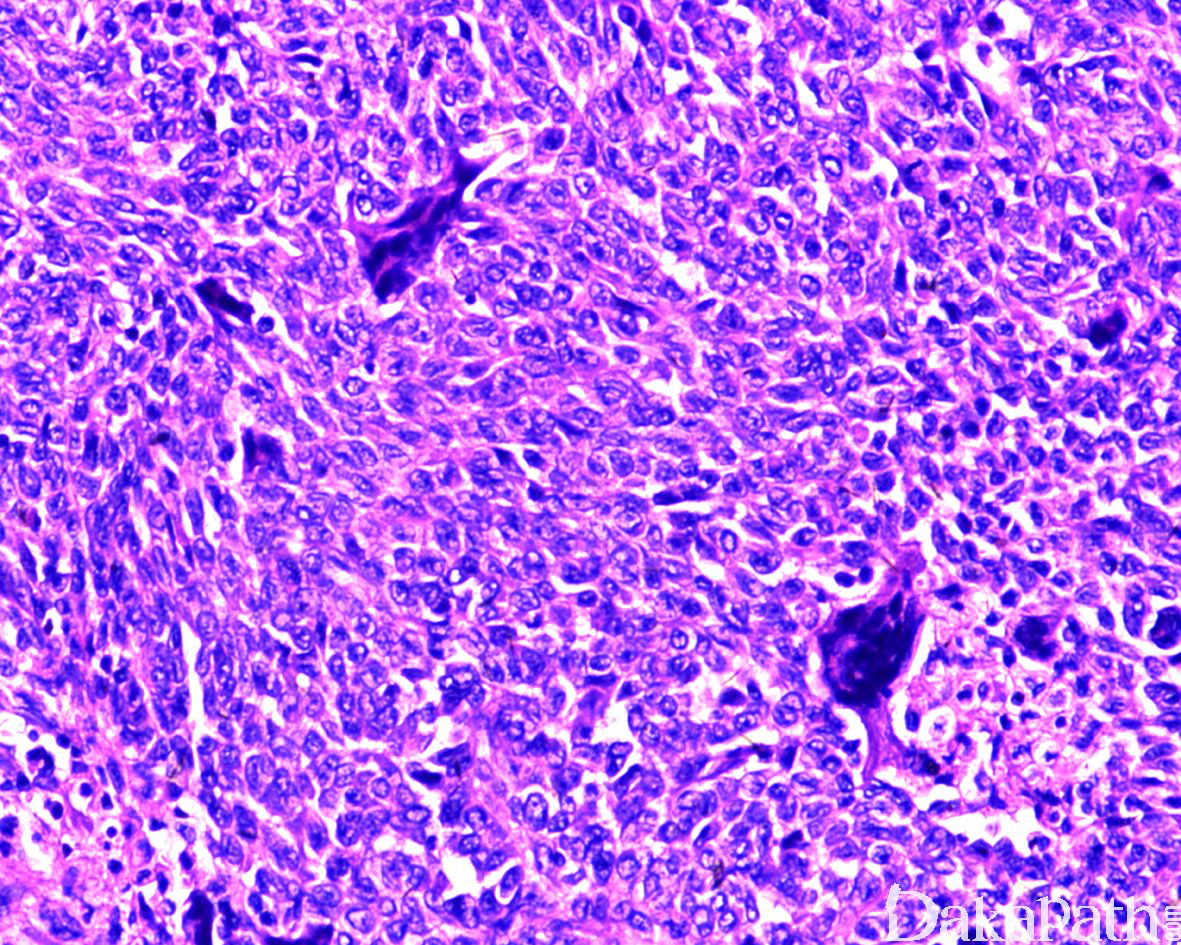

恶性胃肠道神经外胚层肿瘤
malignant gastrointestinal neuroectodermal tumor (MGNET)
同义词(或曾用名): 胃肠道透明细胞肉瘤样肿瘤;胃肠道富于破骨样巨细胞类似于软组织透明细胞肉瘤的肿瘤
概述:
发生在胃肠道、在形态学上与软组织透明细胞肉瘤明显相似,免疫组化染表达原始神经嵴和神经内分泌标志物,遗传学上具有 EWSR1-CREB1 或 EWSR1-ATF1 融合基因的过表达,超微结构上显示原始神经外胚层细胞特征、无黑色素生成的证据
发病部位: 小肠最为多见(回肠和空肠为主),其次为胃和食管,结直肠及腹膜少见
诊断要点:
好发于年轻成人(10 岁~ 81 岁,中位年龄约 35 岁),无性别好发倾向;所有病例均位于腹腔内,以小肠最为多见(回肠和空肠为主),其次为胃和食管,结直肠及腹膜少见;
表现为腹痛、肠梗阻或腹腔内肿块等非特异性症状;
大体上肿瘤一般位于肠壁固有肌层透壁或环周生长,较大的肿瘤可见凸向肠腔呈息肉样伴粘膜溃疡形成;瘤体直径 2.4 ~ 15cm(中位大小约 4.5cm),切面实性灰白多结节状,常伴有不同程度的出血、坏死或囊性变。
镜下,肿瘤呈片状和多结节状于肌层浸润,常见浆膜和粘膜累及;
肿瘤由弥漫一致的小圆至中等大上皮样细胞组成,胞浆弱嗜酸性,稀少至中等量,部分病例可见透明胞浆;其它常见的组织学构型包括假腺泡、假乳头、微囊、束状以及梁状结构;罕见的情况下可见顿挫的菊形团样结构,提示其神经外胚层分化的证据;
瘤细胞胞浆稀少,偶见丰富的嗜酸性胞浆,核浆比例高,核呈空泡状伴染色质边集,常见细小核仁;
核分裂象一般比较活跃(平均 6 个/10 高倍镜视野),常见不同程度的肿瘤性坏死;
MGNET 高度特征性的组织学表现为肿瘤内散在分布的破骨样巨细胞,与肿瘤细胞具有不同的核形态提示其反应性本质。破骨样巨细胞在不同肿瘤之间甚至同一肿瘤的不同区域之间分布具有明显的差异,有时候低倍镜下即可明显感知,有时需要更高倍数的视野仔细观察,有些病例可能完全缺如,特别是在活检标本中更是如此.

免疫组织化学染色:
一致性的表达 S100 和 SOX10,前者从斑驳状阳性至弥漫强阳性不等,后者几乎总是弥漫强阳性;约 76%表达至少 1 项下列神经内分泌标注物(CgA、Syn、CD56 或者神经元特异烯醇化酶);瘤细胞不表达黑色素细胞标志物(HMB45 和 Melan-A);一般不表达上皮、胃肠道间质瘤标志物(DOG1. CD117 和 CD34)、尤文氏肉瘤标志物(CD99. Fli-1 和 ERG)以及肌源性标志物(SMA、Desmin 和 H-caldesmon)等。
分子标记:
90%的 MGNET 存在 EWSR1 基因重排,t(12;22)(q13;q12)和 t(2;22)(q32.3;q12)易位分别导致 EWSR1-ATF1 和 EWSR1-CREB1 融合基因的过表达
鉴别诊断:
表1 恶性GNET组织学、免疫表型和遗传学鉴别诊断要点 | |||||||||||
肿瘤类型 | 组织学鉴别诊断要点 | S100 | SOX10 | HMB45/Melan-A | SMA/Desmin | CK/EMA | CD117 | DOG-1 | CD99 | EWSR1重排 | SYT重排 |
恶性GNET | 小圆蓝或短梭形细胞,核仁小,假腺泡、假乳头、微囊结构,破骨样巨细胞 | + | + | - | - | - | - | - | - | + | - |
透明细胞肉瘤 | 片状、梁状或巢状结构,核仁大而明显,多核瘤巨细胞(非破骨样巨细胞) | + | + | + | - | - | - | - | - | + | - |
黑色素瘤 | 多种组织学构型,散在色素沉积,核仁大而明显 | + | + | + | - | - | +/- | - | - | - | - |
胃肠道间质肿瘤 | 上皮样或梭形细胞,束状结构更明显,罕见溃疡形成 | -/+ | - | - | -/+ | - | + | + | - | - | - |
滑膜肉瘤 | 上皮样腺腔或条索以及缎带,血管外皮瘤样结构,散在肥大细胞 | -/+ | - | - | -/+ | + | - | - | +/- | - | + |
PEComa | 梭形或透明细胞,血管丰富,血管周生长方式 | +/- | - | + | + | - | - | - | - | - | - |
MPNST | 核波浪状;深浅交替分布,漩涡状排列 | + | + | - | - | - | - | - | - | - | - |
尤文氏肉瘤/PNET | 核大小一致,胞浆富于糖原,染色质细腻 | +/- | - | - | - | -/+ | - | - | + | + | - |
GNET:胃肠道神经外胚层肿瘤;PEComa:血管周具有上皮样细胞分化的肿瘤; MPNST:恶性外周神经鞘膜瘤;PNET:原始神经外胚层肿瘤 | |||||||||||
治疗:
治疗上首选手术切除并在术后影像学密切监控和随访,到目前为止,术后辅助治疗在恶性 GNET 中的经验尚有限,文献中仅有 1 例合并结肠腺癌的恶性 GNET 术后接受 5-&l
病例报道:
Boland J M, Folpe A L. Oncocytic variant of malignant gastrointestinal neuroectodermal tumor: a potential diagnostic pitfall [J]. Hum Pathol, 2016, 57(13-6. 参考文献:
Stockman D L, Miettinen M, Suster S, et al. Malignant gastrointestinal neuroectodermal tumor: clinicopathologic, immunohistochemical, ultrastructural, and molecular analysis of 16 cases with a reappraisal of clear cell sarcoma-like tumors of the gastrointestinal tract [J]. Am J Surg Pathol, 2012, 36(6): 857-68. 赵明 ,赵同伟,马杰,伍翠云,陈磊,茹国庆,何向蕾. 恶性胃肠道神经外胚层肿瘤临床病理和分子特征分析. 中华病理学杂志 .2017;46(11):750-755.
